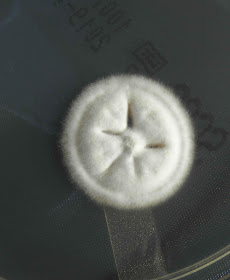

O Histoplasma capsulatum é um fungo dimórfico. Apresenta-se como um fungo ubiquitário, contudo existem áreas geográficas onde se constitui como um problema infeccioso endémico - a principal região é ao longo do vale dos rios Mississipi e Ohio. Na natureza encontra-se frequentemente associado a excrementos de pássaros e morcegos.
O H. capsulatum provoca uma infecção intracelular das células do sistema reticulo-endotelial com origem na inalação de esporos. É possível observar células leveduriformes gemuladas no interior destas células que durante a infecção se multiplicam em grande número podendo substituir o tecido normal. A maioria das infecções são assintomáticas e benignas, cerca de 5% podem transformar-se em infecções crónicas progressivas, pulmonares, cutâneas ou sistémicas. Frequentemente mimetizam a infecção por Mycobacterium tuberculosis. Crianças e imunodeprimidos apresentam um risco aumentado de infecção.
Reactivação com origem endógena pode ocorrer 2 a 3 décadas após a infecção primária
Esta estirpe foi isolada em secreções da árvore respiratória de um doente HIV residente em Lisboa mas com um passado recente de residência no Brasil.
A análise macroscópica revela uma colónia com textura granular ligeiramente algodonosa, inicialmente é branca mas com o tempo vai adquirindo um tom acastanhado sendo o reverso creme.
A análise microscópica do micélio revela a presença de macroconideos e microconideos. Os microconideos são sésseis ou com origem num pequeno pedunculo. Os macroconideos apresentam uma forma semelhante aos clamidosporos e tem origem em curtos conidióforos, possuem apenas uma célula com parede dupla da qual saiem, passados alguns dias de incubação (a maturação total é lenta podendo ser necessário esperar 4 a 8 semanas), projecções cilindricas em toda a circunferência.
Estirpe gentilmente cedida pela Drª Dinah Corte Real, do Serviço de Patologia Clínica do Centro Hospitalar Lisboa Norte. A estirpe foi isolada numa amostra biológica de um doente e examinada no laboratório de microbiologia do referido Serviço.
 |
| Colónia com 18 dias de incubação. |
|
| Colónia com 18 dias de incubação. |
 |
| Colónia com 18 dias de incubação. |
 |
| Colónia com 18 dias de incubação. |
 |
| Reverso de colónia com 18 dias de incubação. |
 |
| Colónia com 30 dias de incubação. |
 |
| Colónia com 30 dias de incubação. |
 |
| Colónia com 30 dias de incubação. |
 |
| Ampliação 1000x . Macroconidios - (origem em colónia <30 dias de incubação) |
 |
| Ampliação 1000x . Macroconidios - (origem em colónia <30 dias de incubação) |
 |
| Ampliação 1000x . Macroconidios - (origem em colónia <30 dias de incubação) |
 |
| Ampliação 1000x . Macroconidios - (origem em colónia <30 dias de incubação) |
 |
| Ampliação 1000x . Macroconidios - (origem em colónia <30 dias de incubação) |
 |
| Ampliação 1000x . Macroconidios - (origem em colónia <30 dias de incubação) |
 |
| Ampliação 1000x . Macroconidios - (origem em colónia <30 dias de incubação) |
 |
| Ampliação 1000x . Macroconidios - (origem em colónia <30 dias de incubação) |
 |
| Ampliação 1000x . Macroconidios - (origem em colónia <30 dias de incubação) |
 |
| A mesma macroconidea fotografada em 3 planos sucessivos - (origem em colónia >30 dias de incubação) . |
 |
| Ampliação 1000x . Macroconidios - (origem em colónia >30 dias de incubação) |
 |
| Ampliação 1000x . Macroconidios - (origem em colónia >30 dias de incubação) |
 |
| Ampliação 1000x . Macroconidios - (origem em colónia >30 dias de incubação) |
 |
| Ampliação 1000x . Macroconidios - (origem em colónia >30 dias de incubação) |
 |
| Gelose de sangue - fase leveduriforme. |
 |
| Gelose de sangue - fase leveduriforme. |
 |
| Microscopia de colónia da fase leveduriforme. |
 |
| Microscopia de colónia da fase leveduriforme. |
 |
| Microscopia de colónia da fase leveduriforme. |
 |
| Microscopia de colónia da fase leveduriforme. |
 |
| Microscopia de colónia da fase leveduriforme. |
 |
| Microscopia de colónia da fase leveduriforme. |
 |
| Microscopia de colónia da fase leveduriforme. |
 |
| Microscopia de colónia da fase leveduriforme. |
 |
| Microscopia de colónia da fase leveduriforme. |
Sem comentários:
Enviar um comentário